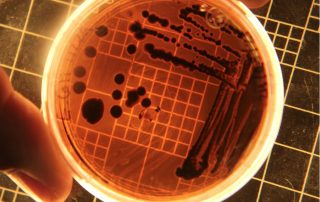
spore.bio

La start-up Spore.Bio ha raccolto un finanziamento di 23 milioni di dollari per il rilevamento rapido di batteri nei cosmetici
Parigi (Francia) – La startup francese con sede a Parigi [...]
Cambio al vertice di Unilever: lascia Schumacher, arriva Fernandez
Amsterdam (Paesi Bassi) – Dopo solo due anni in carica, Hein Schumacher (foto) [...]
Bismuto: limitazioni all’export in Cina portano i prezzi in Ue al picco più alto dal 2008
Bruxelles (Belgio) – Il prezzo del bismuto, metallo utilizzato in cosmetica, [...]
Shrinkflation, l’obbligo di avviso sulle confezioni slitta di sei mesi
Roma – Il Ddl concorrenza aveva fissato all’1 aprile l’obbligo [...]
L’Oréal Italia collabora con SamyRoad per la gestione delle attività di influencer marketing
Milano – SamyRoad, parte di Samy Alliance, è l’agenzia di [...]
Materiali packaging di piccolo formato: un consorzio per il riciclo per i settori beauty e alimentare
New York (Usa) – Closed Loop Partners ha pubblicato un [...]